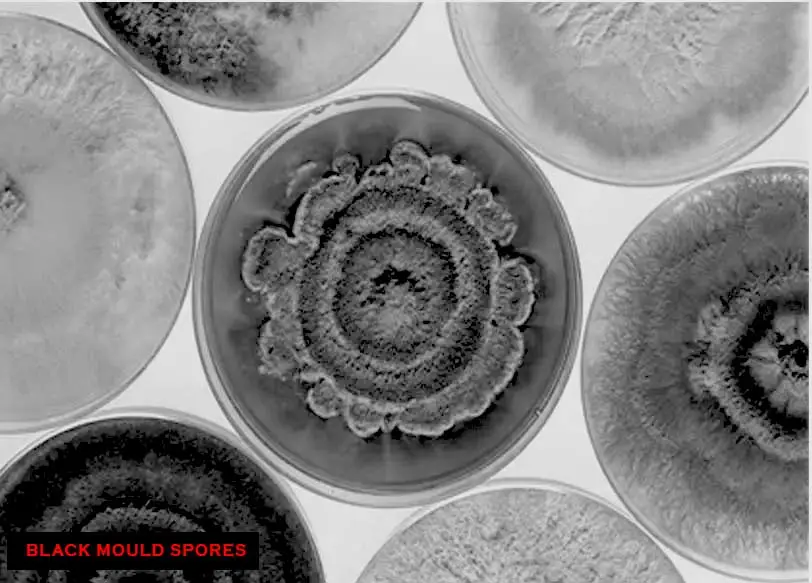
microscopic image of mould

Google advises us about trickle vent installation costs using questionable information.
This information is not correct. If a window ventilation service is delivered professionally, as it should be, then the installation will depend on the size of the room and any mitigating factors regarding ventilation in the property. Our approach is 100% professional and FULLY complies with the amended 2022 UK building regulation legislation.
When searching for trickle vents on google we see the prices below

Many of these products were manufactured BEFORE the latest 2022 U.K. building regulations.
Introducing our own manufactured, game-changing solution for improved home ventilation, made in England:
The Easy Glazed Trickle Vent. Designed to fit seamlessly into your existing windows, these ingenious devices offer a myriad of benefits that will make you wonder how you ever lived without them!
After the regulations were amended in 2022, the installation of trickle vents became a more in depth process. The legislation stipulates a non negotiable legal requirement for ventilation levels. Naturally this demands careful analysis, measurement and planning. Easy Glazed Trickle Vents are always installed to the very highest legal standards. We do the job properly! No short cut hole drilling, no low quality trickle vents! Just professional installations performed by highly experienced trickle vent experts.
First and foremost, the Easy Glazed Trickle Vent's cutting-edge design allows for constant, gentle air circulation throughout your home. No more stuffy rooms or lingering odours! Experience fresher and healthier indoor air quality in every corner of your living space.

Easy Glazed Trickle Vents have got you covered! By promoting steady air movement, our vents help control moisture levels and limits the damp conditions that mould loves. Say goodbye to unchallenged fully thriving mould spores around your unventilated windows! Breathe easier knowing you did what you could to improve conditions and help keep your family safe and sound
Why do windows often suffer from mould problems? The answer lies in the temperature differences between your cosy home and the outside world. When warm, moist air from inside meets the cold glass of your windows, it cools down and creates the perfect breeding ground for mould. If left unchallenged, mould spores can quickly thrive producing the unsightly mould marks you often see on walls or even behind chairs and furniture. Our Easy Glazed Trickle Vents nip this problem in the bud by maintaining a consistent appropriate airflow that regulates humidity and keeps your windows dry. We calculate the required airflow for your rooms according to UK building regulation guidelines. We've got you covered from all angles!

No need for expensive renovations or time-consuming construction work – We can work with your existing windows! just sit back, relax, and let our experts take care of the rest. You'll be enjoying the incredible benefits of improved ventilation in no time!
Our professional friendly installers will replace your glass and properly insert the trickle vent into the window. We do not cut corners by drilling holes in your existing windows. We calculate the airflow your room needs, we do it scientifically and effectively. You can rely on Easy Glazed Trickle Vents to freshen up your life in a cost effective and professional manner!!
Check out our string of satisfied customers and our social media engagement for more information
Why wait?
Invest in Easy Glazed Trickle Vents today, and transform your home
Easy Glazed Trickle Vents offer a simple, innovative solution to transform your living space into the fresh, healthy haven you’ve always dreamed of. Say goodbye to poor air quality and unwelcome mould—take charge and let the benefits flow!
CALL US NOW
Landlords have a legal duty to adequately ventilate properties for their tenants. Call us for more information on this